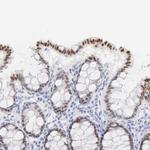
ELF3 Antibody in Immunohistochemistry (Paraffin) (IHC (P))

Search
Invitrogen
ELF3 Polyclonal Antibody
{{$productOrderCtrl.translations['antibody.pdp.commerceCard.promotion.promotions']}}
{{$productOrderCtrl.translations['antibody.pdp.commerceCard.promotion.viewpromo']}}
{{$productOrderCtrl.translations['antibody.pdp.commerceCard.promotion.promocode']}}: {{promo.promoCode}} {{promo.promoTitle}} {{promo.promoDescription}}. {{$productOrderCtrl.translations['antibody.pdp.commerceCard.promotion.learnmore']}}
图: 1 / 7
ELF3 Antibody (PA5-82098) in IHC (P)

产品信息
PA5-82098
种属反应
宿主/亚型
分类
类型
抗原
偶联物
形式
浓度
规格
纯化类型
保存液
内含物
保存条件
运输条件
RRID
产品详细信息
Immunogen sequence: ATCEISNIFS NYFSAMYSSE DSTLASVPPA ATFGADDLVL TLSNPQMSLE GTEKASWLGE QPQFWSKTQV LDWISYQVEK NKYDASAIDF SRCDMDGATL CNCALEELRL VFGPLGDQLH AQLRDLTSSS SDELSWIIEL LEKDGMA
Highest antigen sequence indentity to the following orthologs: Mouse - 86%, Rat - 74%.
靶标信息
ESE-1 (Epithelium-Specific Ets) is a novel, highly tissue-restricted member of the ets transcription factor/oncogene family, which has features distinct from those of any other ets-related factor. ESE-1 binds with high affinity to and transactivates the ets binding site in the promoter of the keratinocyte terminal differentiation marker gene, SPRR2A. ESE-1 is a critical regulator of epithelial cell differentiation.
仅用于科研。不用于诊断过程。未经明确授权不得转售。
篇参考文献 (0)
生物信息学
蛋白别名: AT2G25930; E74-like factor 3; E74-like factor 3 (ets domain transcription factor); E74-like factor 3 (ets domain transcription factor, epithelial-specific ); E74-like factor 3 (ETS domain transcription factor, serine box, epithelial-specific); EARLY FLOWERING 3; ELF3; Epithelial-restricted with serine box; Epithelium-restricted Ets protein ESX; Epithelium-specific Ets transcription factor 1; ESE-1; ets domain transcription factor, serine box (epithelial-specific); ETS-related transcription factor Elf-3; F17H15.25; jen; PYK20; RP11-510N19.1; unnamed protein product
基因别名: ELF3; EPR-1; ERT; ESE-1; ESX; JEN
UniProt ID: (Human) P78545
Entrez Gene ID: (Human) 1999




